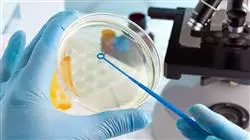
##IMAGE##

Titolo universitario
La più grande facoltà di medicina del mondo"
Presentazione
Con questa qualifica, aumenterai le tue competenze nell'uso di metodi come l'High-Throughput o la Real-Time PCR per gli studi genetici"

La Nutrizione Genomica si è progressivamente affermata nel campo della Medicina come metodo efficace per prevenire varie malattie o per stabilirne il trattamento. Le tecniche utilizzate in laboratorio per effettuare studi genetici si sono evolute in modo significativo, con l'obiettivo di realizzarli in tempi brevi e con un livello di accuratezza superlativo. Poiché da questo lavoro dipenderà non solo il successo dell'analisi, ma anche l'ottimizzazione della successiva terapia con il paziente, i medici devono essere consapevoli di questi progressi e applicarli correttamente nel loro lavoro quotidiano per perfezionare il loro sviluppo professionale nel mondo della Nutrizione Genomica.
TECH ha deciso di creare questa qualifica, con la quale lo studente adotterà tecniche di laboratorio innovative che consentono di effettuare studi sul DNA in modo rapido, semplice e con ottimi risultati, per poter poi adattare con successo la dieta alle caratteristiche genetiche di ogni persona. Durante 6 settimane di insegnamento intensivo, imparerai i protocolli più aggiornati per il sequenziamento del DNA o conoscerai i biomarcatori della Metabolomica o della Metagenomica. Utilizzerai, inoltre, software e strumenti bioinformatici all'avanguardia per il reperimento e l'archiviazione dei dati genetici ottenuti.
Grazie alla metodologia 100% online che caratterizza questo corso universitario, lo studente sarà in grado di gestire il proprio tempo secondo i propri ritmi per ottenere un apprendimento pienamente efficiente. Avrai accesso a contenuti didattici disponibili su supporti come letture supplementari o video esplicativi, in modo da poter adattare l'insegnamento alle tue particolari esigenze di studio.
Il corso universitario in Tecniche di Laboratorio per Nutrizione Genomica ti consentirà di gestire con precisione i biomarcatori della Metabolomica o della Metagenomica"
Questo corso universitario in Tecniche di Laboratorio per Nutrizione Genomica possiede il programma scientifico più completo e aggiornato del mercato. Le caratteristiche principali del programma sono
- Lo sviluppo di casi di studio presentati da esperti in Nutrizione Genomica e di Precisione
- Contenuti grafici, schematici ed eminentemente pratici che forniscono informazioni scientifiche e pratiche sulle discipline essenziali per l’esercizio della professione
- Esercizi pratici che offrono un processo di autovalutazione per migliorare l'apprendimento
- Particolare enfasi sulle metodologie innovative
- Lezioni teoriche, domande all'esperto, forum di discussione su questioni controverse e compiti di riflessione individuale
- Contenuti disponibili da qualsiasi dispositivo fisso o mobile dotato di connessione a internet
Combina il tuo apprendimento con i tuoi impegni professionali e lavorativi grazie alla modalità di erogazione completamente online di questa qualifica"
Il personale docente del programma comprende rinomati specialisti del settore e altre aree correlate, che forniscono agli studenti le competenze necessarie a intraprendere un percorso di studio eccellente.
Contenuti multimediali, sviluppati in base alle ultime tecnologie educative, forniranno al professionista un apprendimento coinvolgente e localizzato, ovvero inserito in un contesto reale.
La creazione di questo programma è incentrata sull’Apprendimento Basato su Problemi, mediante il quale lo specialista deve cercare di risolvere le diverse situazioni che gli si presentano durante il corso. Sarai supportato da un innovativo sistema video interattivo sviluppato da esperti rinomati.
Assimila i più aggiornati protocolli di sequenziamento del DNA grazie a questo corso universitario che TECH ti offre"

Con un semplice smartphone dotato di connessione a internet potrai seguire questo programma ovunque ti trovi"
Obiettivi e competenze
Incorpora gli ultimi progressi nelle Tecniche di Laboratorio per la Nutrizione Genomica nella tua metodologia di lavoro"
Obiettivi generali
- Acquisire conoscenze teoriche sulla genetica umana di popolazioni
- Acquisire conoscenze sulla Nutrizione Genomica e di Precisione per poterle applicare nella pratica clinica
- Imparare la traiettoria di questo campo innovativo, e gli studi chiave che contribuiscono al suo sviluppo
- Conoscere in che patologie e condizioni della vita umana si possa applicare la Nutrizione genomica e di precisione
- Poter valutare le risposta individuale alla nutrizione e i modelli dietetici al fine di promuovere la salute e la prevenzione delle malattie
- Conoscere come la nutrizione influisca sull’espressione genica umana
- Conoscere nuovi concetti e tendenze future nel campo della Nutrizione Genomica e di Precisione
- Poter adeguare abitudini alimentari e di vita personalizzati in base ai polimorfismi genetici
- Fornire ai professionisti sanitari tutte le conoscenze aggiornate sul campo della Nutrizione Genomica e di Precisione, affinché sappiano applicarle nella loro attività professionale
- Mettere in prospettiva tutte le conoscenze aggiornate Comprendere in che momento ci troviamo e dove Se stiamo dirigendo, affinché lo studente possa apprezzare le implicazioni etiche, economiche e scientifiche del campo
Obiettivi specifici
- Capire le tecniche utilizzate negli studi di Nutrigenomica
- Padroneggiare le più moderne tecniche di estrazione del DNA
- Acquisire gli ultimi progressi nella bioinformatica
- Utilizzare i software e gli strumenti bioinformatici più aggiornati

Seguendo gli obiettivi generali e specifici che TECH ha delineato per questa qualifica, adotterai una serie di competenze che ti aiuteranno a perfezionare le tue prestazioni in laboratorio"
Corso Universitario in Tecniche di Laboratorio per Nutrizione Genomica
Scopri l'affascinante campo della nutrizione genomica e acquisisci le competenze tecniche necessarie con il Corso Universitario in Tecniche di Laboratorio per Nutrizione Genomica di TECH Università Tecnologica. Focalizzato sulla professionalità training, questo programma ti offre l'opportunità di ampliare le tue conoscenze online, sfruttando tutti i vantaggi che questa modalità ha da offrire. Il Corso Universitario in Tecniche di Laboratorio per Nutrizione Genomica ti fornisce una preparazione specialistica sulle tecniche e sugli strumenti di laboratorio più utilizzati nel campo della nutrizione genomica. Imparerai a utilizzare apparecchiature e software all'avanguardia, eseguire analisi di campioni biologici e interpretare i risultati ottenuti. Acquisirai competenze pratiche e teoriche che ti permetteranno di contribuire al progresso della ricerca in questo campo d'avanguardia. Il nostro programma ha un team di professori esperti nel campo della nutrizione genomica e con esperienza in laboratori di ricerca. Inoltre, avrai accesso a risorse tecnologiche all'avanguardia, come laboratori virtuali e database specializzati, che ti forniranno un'esperienza di apprendimento arricchente e aggiornata. Al completamento del Corso Universitario in Tecniche di Laboratorio per Nutrizione Genomica, sarai pronto ad applicare le tue conoscenze in laboratori di ricerca, cliniche specializzate in nutrizione, aziende biotecnologiche e altri ambienti professionali correlati. Potrai eseguire analisi genetiche e molecolari, interpretare i risultati ottenuti e contribuire allo sviluppo di strategie nutrizionali personalizzate basate sulla genomica.
Iscriviti ora e inizia a crescere nella tua carriera professionale
TECH Università Tecnologica comprende l'importanza della flessibilità e dell'accessibilità nell'istruzione. Il nostro programma online ti consente di studiare ovunque e in qualsiasi momento si adatti al tuo programma. Non dovrai più preoccuparti di spostamenti, orari rigidi o barriere geografiche. Potrai apprendere al tuo ritmo, sfruttando al massimo il tuo tempo e adattando i tuoi studi ai tuoi impegni personali e professionali.







